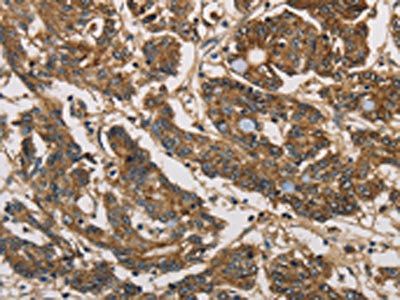
UBE2S Antibody

You have no items in your shopping cart.
Human UBE2S
SKU: orb2993568
Description
Images & Validation
−
Key Properties
−| Expression System | E.coli |
|---|---|
| Biological Origin | Human |
| Tag | N-GST |
| Molecular Weight | Predicted: 50.13 KDa. Observed: 50 KDa, reducing conditions |
| Expression Region | Met1-Leu222 |
| Purity | SDS-PAGE: Greater than 95% as determined by reducing SDS-PAGE. |
| Endotoxins | < 1 EU/µg as determined by LAL test. |
| Conjugation | Unconjugated |
Storage & Handling
−| Storage | Store at ≤-70°C, stable for 6 months after receipt. Store at ≤-70°C, stable for 3 months under sterile conditions after opening. Please minimize freeze-thaw cycles. |
|---|---|
| Form/Appearance | Supplied as a 0.2 μm filtered solution of 50mM HEPES, 150mM NaCl, 2mM DTT, 10% Glycerol, pH 7.5. |
| Disclaimer | For research use only |
Alternative Names
−Ubiquitin-Conjugating Enzyme E2 S; E2-EPF; Ubiquitin Carrier Protein S; Ubiquitin-Conjugating Enzyme E2-24 kDa; Ubiquitin-Conjugating Enzyme E2-EPF5; Ubiquitin-Protein Ligase S; UBE2S; E2EPF
Similar Products
−UBE2S Antibody [orb520715]
ELISA, IHC, WB
Human, Mouse, Rat
Rabbit
Polyclonal
Unconjugated
50 μl, 100 μl

Quality Guarantee
Explore bioreagents carefree to elevate your research. All our products are rigorously tested for performance. If a product does not perform as described on its datasheet, our scientific support team will provide expert troubleshooting, a prompt replacement, or a refund. For full details, please see our Terms & Conditions and Buying Guide. Contact us at [email protected].
Quick Database Links
UniProt
UniProt Details
− No UniProt data available
Documents Download
Datasheet
Product Information
Request a Document
Protocol Information
Human UBE2S (orb2993568)
Based on 0 reviews
Participating in our Biorbyt product reviews program enables you to support fellow scientists by sharing your firsthand experience with our products.
Login to Submit a Review